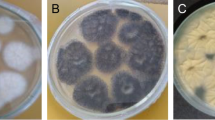

Abstract
Exo-polygalacturonase was produced from a fungal strain Penicillium paxilli under solid-state fermentation (SSF) technique using wheat and rice bran (1:1) as a substrate. Production optimization data suggested that yeast extract, pectin, and manganese sulfate significantly enhanced the exo-polygalacturonase yield. This enzyme was partially purified using NH4(SO4)2 precipitation at 70% saturation level and characterized in terms of various parameters. The pH optima shifted from 3.5 to 6.5, while transition in temperature optimum was observed from 35 to 40 °C in case of immobilized enzyme. After immobilization at 70 °C, a 16% and 15% increase in values of half-life and enthalpy (ΔH*), respectively, and 2.25% decrease in Gibbs free energy (ΔG*) values were observed. Km value was observed to be 0.084 µmoles/mL/min with a 33% decline in Vmax value for immobilized exo-polygalacturonase. Immobilization showed 47% retention in bioactivity even at the 5th cycle of reuse. Results of different fruit juice treatment with exo-polygalacturonase showed that total phenolic and antioxidant contents of pomegranate and grapes juice were enhanced by 256% and 18%, respectively, while a 93% increase in clarification and 55% reduction of viscosity were observed in the case of grape and pineapple juices after enzymatic treatment. Finally, it can be concluded that this exo-polygalacturonase showed a good performance in the case of thermal stability and can be successfully implemented as an excellent candidate to be used in the fruit juice industry.
Similar content being viewed by others
Explore related subjects
Discover the latest articles, news and stories from top researchers in related subjects.Avoid common mistakes on your manuscript.
1 Introduction
Since the beginning of fruit juice technology, pectinolytic enzymes have been of utmost importance. These enzymes are used to aid in clarifying and extracting juices from a variety of fruits. In developing countries, rapid industrialization occurred in citrus-producing and processing sectors like oils, juices, and other products [1]. A variety of fruits juices for human consumption are procured on a global scale, and among these include mango, apple, citrus, dates, bananas, pineapples, peach, and oranges [2]. Crystal-clear juices with improved transparency are being produced commercially due to high commercial demand at an annual scale in the world market. To increase a fruit juice yield with enhanced transparency level, some parameters like reduction in filtration time, increased volume, viscosity, turbidity reduction, and juice clarification are the factors that make the depolymerase-assisted biocatalytic processes appealing in fruit juice processing industry [3]. Higher plants and microorganisms contain many pectinolytic enzymes, which play a vital role in softening some plant tissues and cell wall extension during storage and maturation [4].
Pectinolytic enzymes that catalyze the hydrolytic degradation of the α-1, 4-glycosidic bonds are polygalacturonase (PG) and cause pectin degradation [5]. Upon degradation, pectin produces 60–90% galacturonic acid, galactose, some pentoses acetic acid, and methanol [6]. Polygalacturonases are categorized into two forms by substrate specificity and bond position. Endopolygalacturonase indiscriminately hydrolyzes the polymeric α-1,4-glycosidic linkages/bonds, while exo-polygalacturonase acts from the non-reducing end [7]. Natural sources for Exo-polygalacturonase are fungi, yeast, bacteria, plants, nematodes, protozoa, and insects [8]. Higher plant’s structural backbone is constructed of polysaccharides which are pectic substances and are primarily present in the primary cell wall and middle lamella. These structural polysaccharides consist of alpha (1–4) linked D-galacturonic acid monomers containing rhamnose residues in the central chain [9].
The large-scale production of pectinases is from fungal resources using fermentation technology [10]. Industrial-scale pectinase production occupies about 10% of the overall fermentation of various enzyme preparations having commercially significant value. Pectinases are required to clarify fruit juices due to their ability to reduce bitterness, cloudiness, and viscosity, resulting in enhanced press ability and reduction in jelly-like consistency of pectin [1]. They are extensively used in the paper and pulp industry, treatment of wastewater having pectinaceous materials, degumming and retting process of plant bast fibers, bio-bleaching of cotton fibers, textile processing, coffee, tea fermentation, animal feed, plant disease control, oil extraction, liquefaction, in dietary fibers, antioxidants and phytonutrients study, fruit juice clarification, viscosity and turbidity reduction, and improvement of clarity index [10,11,12].
Some limiting factors are always involved in the industrialization of enzymes which should be overcome via developing different methods and strategies. These inadequacies include availability of pectinases with desired processing characteristics, lack of biocatalyst stability during processing in harsh industrial environments, difficulty in recovery and reusability, and the high production costs of enzymes [13,14,15]. One of the most crucial research areas working with pectinases is to impart improved thermostability via some immobilization techniques which was initially designed to recover and reuse the enzyme from reaction medium [16, 17] because enzymes were quite expensive initially. Later, it was explored that immobilization of enzymes can also be linked with continuous operation procedures, which is highly favored in industrial environments. So, immobilization provides enhanced thermal stability, better storage, better operational control, flexibility of reactor design, conformational stability, and easy recovery of the enzymes from the reaction mixture [13, 18]. A successful enhancement of enzymatic features via immobilization support material has resolved the problem of highly stable multifunctional commercial enzyme features that usually lack free/soluble enzymes. Creation of immobilized enzymes is a “mimicry” of their natural mode in living cells, where most of them are attached to a support of cellular cytoskeleton/membrane structures/organelles. The solid support systems generally stabilize and retain the structure of the enzymatic proteins, leading to the maintenance of their bioactivities. As compared to free counterparts, immobilized biocatalysts are more robust and resistant to structural changes. Thus, an immobilized biocatalyst protects itself from becoming exposed to some causes of irreversible inactivation, leading towards operational stabilization. Proteins are distorted when exposed to hydrophobic interfaces, and this interaction is no longer possible if the enzyme is on the inner surface of a porous solid. Enzymes fully immobilized on nonporous nanoparticles are not protected from this negative effect derived from the interaction with hydrophobic surfaces. To get this protection, the coating of the immobilized enzyme molecules with hydrophilic polymers may be an alternative. Immobilization causes reduction in inactivation by partition of some deleterious compounds away from the enzyme molecule via generation of a hydrophilic environment around the enzyme after immobilization. This is the case of the immobilization of enzymes on supports coated with hydrophilic polymers, partitioning some harmful compounds away from the enzyme environment [16, 18,19,20]. An alternative reason for justification of enzyme stabilization upon immobilization is that the enzyme might mimic to be more stable. If the carrier material is overloaded with biocatalyst, its diffusion with substrate molecules might limit the rate of reaction. Substrate molecules will reach the outer layers of biocatalyst only before it is converted into products. Once enzyme loses activity, the substrate will have to diffuse further into the enzyme layers/carrier material before it is converted. Not a big change in activity and reaction rate is observed in this possible reason, so the enzyme appears to be more stable [21,22,23,24,25,26].
Magnetic nanoparticles (MNPs) are recently in demand due to their immobilizing and quantum properties and increased surface/volume ratio. They can be reused easily after recovery from the reaction medium using an applied magnetic field. Nanoparticles firmly control the material’s properties, such as stiffness and elasticity, and provide biocompatible environment for enzyme immobilization [27, 28]. It is also mandatory to use a non-toxic, biocompatible, and environment-friendly approach to immobilize pectinases, which are food-grade enzymes. So, chitosan, a biopolymer, was used to prepare the stabilized and biocompatible magnetic nanoparticles. Biocatalyst immobilized on non-porous surfaces shows some interaction with hydrophobic interfaces within the reaction media leading towards protein denaturation/disruptions, which is quite opposite to the purpose of immobilization and this issue can be resolved by coating the immobilized enzymes with some hydrophilic polymers like aldehyde dextran (non-toxic and biodegradable cross-linker), which not only host the enzyme on non-porous material but also protect it from microenvironments of the reaction media leading towards improved stabilization at elevated temperatures and pH [18, 29]. Various authors have suggested that immobilization of pectinase on functionalized MNPs could potentially improve the thermal stability and functionality of enzymes at elevated temperatures.
So, keeping in mind the immense industrial potential of this enzyme, this study was conducted for exo-polygalacturonase biosynthesis via Pencillium paxilli, which was optimized via various factors under solid-state fermentation technology. It was partially purified via salting out using ammonium sulfate precipitation and was biochemically characterized by various kinetic and thermodynamic parameters. The next step was immobilized onto chitosan nanosupport to enhance its thermal stability characteristics. Its industrial assessment was done by treating various seasonal and local fruit juices to study different nutritional and physical parameters like total phenolic content, antioxidant potential, clarity index, and viscosity reduction.
2 Materials and methods
2.1 Materials
All the chemicals including Na3-Citrate, KH2PO4 anhydrous, K2HPO4, K2HPO4, CaCl2.2H2O, NH4NO3 anhydrous, glucose (C6H12O6), citric acid, ZnSO4.7H2O, Na2MoO4.2 H2O, NaOH anhydrous, potato dextrose agar (PDA), acetic acid, sodium acetate trihydrate (C2H9NaO5), sodium carbonate (Na2CO3), 0.2 N Folin-Ciocalteu reagent, ammonium chloride (NH4Cl), sodium potassium tartrate (KNaC4H4.4H2O), 3, 5 dinitrosalicyclic acids (C7H4N2O7), urea (CH4N2O), methanol (CH3OH), glycine (C2H5NO2), 2,2-diphenyl-1-picrylhydrazyl DPPH (C18H12N5O6), EDTA, chitosan, dextran, ferrous sulfate (FeSO4·4H2O), ferric chloride (FeCl3·6H2O), 2,4 dinitrophenylhydrazine (DNPH), galacturonic acid, sodium meta periodate, pectin, phosphate buffer, glycine–HCl buffer, acetate buffer, glycine-sodium hydroxide buffer, and yeast extract were of analytical grade, and mainly purchased from Sigma-Aldrich.
2.2 Production optimization of exo-polygalacturonase
Fungal strain Penicillium paxilli was procured from fungus bank culture PU, Lahore, and substrate used for exo-polygalacturonase fermentation was a mixture of wheat bran and rice bran (1:1) to be used under solid-state fermentation. Seed culture recipe has the following ingredients: KH2PO4 (5 g/L), NH4NO3 (2 g/L), (NH4)2SO4 (4 g/L), MgSO4.7H2O (0.2 g/L), trisodium citrate (2.5 g/L), yeast extract (0.1 g/L), and glucose at 2% levels, sterilized at 121 °C for about 15 min followed by inoculation under aseptic conditions. Three-day-old culture incubated at 40 °C at 120 rpm was used as inoculum for fermentation. Fundamental factors influencing the exo-polygalacturonase production studied were different sources of carbon at 1% level (pectin, maltose, lactose, glycerin, saccharose, and glucose), nitrogen at 1% level (yeast, ammonium nitrate, glycine, sodium nitrate, ammonium chloride, and ammonium sulfate), and salts at 1% level (manganese sulfate, magnesium sulfate heptahydrate, potassium chloride, potassium dihydrogen phosphate, trisodium phosphate, calcium chloride dehydrate, and sodium chloride). A sterilized and moistened fermentative bed having 10 g of substrate was inoculated with 2 mL of the seed culture medium under aseptic conditions followed by incubation at 40–45 °C for about 3–4 days under static conditions. At the end of fermentation, fermentative bed was harvested by adding 100 mL of phosphate buffer (pH 7.0), shaken at 120 rpm for 1 h at 4 °C followed by ultrafiltration using Whatman filter paper # 1. The filtrate obtained was subjected to enzyme assay and protein estimation.
2.3 Partial purification of exo-polygalacturonase
Enzyme solution obtained after fermentation was subjected to partial purification via ammonium sulfate precipitation at 70% level to reduce the larger volumes of the enzyme. The process of salting-out was carried out at 4 °C overnight in the refrigerator. The very next day, residues were collected by centrifugation at 10,000 rpm at 4 °C for 10 min followed by dialysis overnight at 4 °C using distilled water. Salt-free residue obtained was subjected to protein estimation and enzyme assay for exo-polygalacturonase activity. It was subsequently stored at 4 °C in a refrigerator for use further characterization and immobilization experiments [30].
2.4 Enzyme assay and protein estimation
Exo-polygalacturonase bioactivity was assessed by recording the reducing groups liberated from the pectic backbone of pectinaceous substrate solution using the Dinitrosalicyclic acid (DNS) method [23] using D-Galacturonic acid monohydrate as the standard. A diluted enzyme solution (100 µL) was added to hydrolyze the reaction mixture having pectin solution (0.5%) and 0.05 M acetate buffer having pH 5.5 followed by incubation at 40 °C for about half an hour. Later, this reaction was stopped by adding 1000 µL of DNS reagent followed by immediate heating in a boiling water bath for 10 min. The reducing sugars released in the solution were recorded at 535 nm [31]. Protein estimation and quantification was performed by Bradford assay [32] using bovine serum albumin (BSA) as standard reference.
2.5 Immobilization of exo-polygalacturonase
A total of 50 mL of FeCl3·6H2O (0.32 M) was mixed with 0.2 M FeCl2·4H2O in 1:2 ratio. Then, 1% chitosan solution was added to the reaction mixture with a gradual increase in temperature up to 50 °C followed by gradual addition of 20 mL of 1 M NaOH. Nanoparticles were collected from this reaction via centrifugation after incubation at room temperature for 20 min. Exactly 10 mL of oxidizing agent (0.1 M solution of sodium meta periodate in Na-acetate buffer pH 5.0) was added in 25 g of dextran and kept in the dark for 90 min followed by the addition of 0.3 mL of ethylene glycol and kept it in the dark for 1 h. Oxidized polysaccharide solution, to be used as macromolecular crosslinker, was then dialyzed (in acetate buffer, pH 5.0) at 4 °C overnight [29]. In the final step, nanoparticles were mixed with exo-polygalacturonase solution (4:2, v/v) followed by shaking for 30 min. Then (2.5%, v/v) dextran macromolecular cross-linker was added in the above mixture and incubated at 4 °C for 24 h. A total of 5 mg of sodium borohydrate was added to stop the reaction, followed by incubation for 30 min at 4 °C. Later on, the immobilized exo-polygalacturonase was separated magnetically, washed four times with phosphate buffer (pH 7.0) and subjected to enzyme assay to estimate the bioactivity. The immobilization efficiency was determined in terms of exo-polygalacturonase immobilized, specific activity, and relative activity (%). The amount of biocatalyst loaded/immobilized on support material describes the immobilization technique’s effectiveness in holding the enzyme. This parameter was evaluated by subtracting the amount of protein loaded initially from the amount of protein leaked.
Enzyme/protein immobilized = enzyme introduced for immobilization − enzyme leaked/leached immobilization efficiency (IE) was calculated using the following formula given in equation below.
Relative activity (RA) is another important parameter that determines the efficiency and effectiveness of immobilization technique in terms of relative loss /gain in the bioactivity of the enzyme. It can be calculated using the relationship given below in equation.
2.6 Biochemical characterization of free and immobilized exo-polygalacturonase
2.6.1 Thermodynamic parameters and kinetic constants
Various kinetic and thermodynamic parameters were checked in detail to assess the potential of exo-polygalacturonase for industrial use. So, for this purpose, kinetic constants (km and Vmax) were determined by incubating a fixed amount of enzyme with different concentrations of pectin solution ranging from 0.1 to 2.5% and double reciprocal line-weaver Burk plots were used to interpret the results. The impact of pH on exo-polygalacturonase activity was determined by incubating the enzyme at different pH (2–10) followed by the enzyme assay protocol. The pH stability of exo-polygalacturonase was assessed by incubating the enzyme solution with varying solutions of buffer (pH 2–10) overnight in the refrigerator at 4 °C followed by bioactivity determination the next day [11, 12, 20].
Thermal stability of proteins is a great topic of research and interest because all industrial operations are conducted at a higher temperature scale to fulfill the market demand daily. So, thermal stability of free and immobilized exo-polygalacturonase was examined at different temperatures ranging from 35 to 80 °C via incubation for 60 min at each temperature. Various aliquots of the enzyme were withdrawn at 0 min, 10 min, 20 min, 30 min, 40 min, and 60 min and subsequently kept at 4 °C in the refrigerator overnight to determine its potential to work under drastic conditions. The next day these aliquots were subjected to enzyme assay to obtain/estimate the residual activity at various temperature values. The residual activity of the samples was calculated via following Eq. (1), whereas Ct represents the activity of the enzyme at time t, while Co represents the activity of the enzyme at 0 min, which is a control experiment.
In the next step, different thermodynamic parameters like ΔH*, ΔG*, ΔS*, t1/2, and Ea for thermal denaturation were calculated and determined by plotting graphs via taking residual activity of alginate lyase on the Y-axis and time, t on X-axis for all values of temperatures. The energy of activation (Ea) was calculated by plotting a graph between values of lnkd and 1/T (1000). The enthalpy parameter (ΔH*) was calculated by using the relation given in Eq. 2:
where R = 8.314 J K−1 mol−1 is the universal gas constant and T is the absolute temperature (K).
The free energy of activation (ΔG*) at varying temperatures was determined from the relation shown in Eq. 3:
where h is the Planck’s constant, and its value is 6.62607 × 10−34 Js. kb is Boltzmann constant, and its value is 1.38 × 10−23 J ⋅ K−1.
Activation entropy (ΔS*) was calculated using the formula indicated in Eq. 4:
2.7 Applications of free Exo-PG in the fruit juice industry
To evaluate the Exo-PG potentiality for the food industry, different fruit juices, including apple, pineapple, grapes, and pomegranate, were treated with varying amounts of Exo-PG [33, 34]. Various seasonal fruits were procured from the local market of Faisalabad, and juice extracts were prepared in distilled water. Pulp was separated from juice using a muslin cloth, and a homogeneous mixture was obtained for the enzymatic treatment. Fruit juice samples were incubated in an orbital shaker at 120 rpm at 45 °C for 1 h followed by centrifugation at 10,000 rpm for 10 min. A control experiment was also conducted side by side with the treated sample, and the same volume of distilled water was used in place of the enzyme in the control experiment. The juice sample after enzymatic treatment was subjected to different parameters, i.e., juice yield, clarity index at 660 nm and viscosity measurement using water as a standard reference to see the effect on the quality of produce [12, 34].
2.7.1 Total phenolic and antioxidant contents estimation
To determine the total phenolic contents before and after enzymatic treatment, standard Folin–Ciocaltue method was used by making some alterations in the reported method [26, 27]. Precisely, 30 µL (10% v/v solution prepared in methanol) of fruit juice was added to 150 µL of Folin-Ciocalteu reagent (0.2 N) and mixed for about 10 min. Later, Na-carbonate (0.2 g/mL, 450 µL) was added to the above reaction mixture followed by incubation for about 2 h. The absorbance of this reaction mixture was recorded at 760 nm while using methanol as blank. Gallic acid was used; standard and total phenolic contents were calculated as gallic acid equivalents (GAE) in g/L of fruit juice sample. Total antioxidant contents in control and enzymatically treated juice samples were also assessed in detail, as reported earlier [33]. A total of 3 mL of fruit juice sample (10% v/v solution prepared in methanol) was mixed with 1.5 mL of methanolic DPPH solution having a concentration of 0.02 mg/mL. After incubating the reaction mixture for 15 min at room temperature, the absorbance was recorded at 517 nm using methanol as blank. Finally, the results were expressed as percentage scavenging activity of DPPH.
2.8 Reusability of immobilized pectinase
The reusability study of immobilized pectinase was conducted by performing the activity assay of immobilized pectinase in the pectin solution following incubating its optimized conditions [31]. At the end of each cycle, the resulting solution was subjected to enzyme activity measurements, and the enzyme-bound nanoparticles were magnetically separated from the reaction mixture, washed with phosphate buffer (pH 7.0), and delivered to the next batch of the cycle. The relative activity was used for comparing the activities of each reaction by considering 1st batch activity as 100%.
2.9 Statistical analysis
All experiments were executed in duplicate, and the results were discussed by mean values reported along with standard deviations. Data were subjected to statistical analysis using regression techniques, and analysis of main variance points were highlighted through appropriate graphs. All the data analysis was done using Microsoft Excel (Version-2013).
3 Results and discussions
3.1 Production optimization of Exo-PG
3.1.1 Effect of nitrogen and carbon sources on Exo-PG
Nitrogen is a significant constituent of protein and has a huge impact on enzyme production. Figure 1 represents the enzyme activity by supplementing different nitrogen sources after a fermentation period of 96 h. Among the nitrogen sources ascertained, the inclusion of yeast extract to the fermentation medium furnished the maximum enzyme production, according to earlier reports [35, 36]. On the other hand, ammonium sulfate displayed the least growth in contrast to other nitrogen sources; this could be due to nitrogen being an inorganic source that is not available as it is in the organic form [35]. Our results were not in accordance with [36] because ammonium sulfate showed the least effect on enzyme production. The significant effect of yeast is also beneficial as it can be used in vegetarian foodstuffs production [35].
The addition of carbon sources positively correlated enzyme biosynthesis. Incorporating pectin, maltose, and lactose enhanced the enzyme titers, while glucose and saccharose have the least effect on the improvement of enzyme production (Fig. 2), which might be due to catabolic repression. Pectin and maltose increase the growth of the enzyme to a great extent. Amin et al. [11] studied the effect of the addition of various carbon sources to study the impact on Exo-PG biosynthesis. They utilized a broad range of carbon sources (glucose, pectin, mannitol, sucrose, and glycerol), supplied to the fermentation medium to observe, and assessed their effect on fungus growth and in turn biocatalyst productivity. Their results indicate that glucose, pectin, and mannitol exponentially increased the enzyme titers, whereas the use of glycerol and saccharose reduced the enzyme units and proved to have no significant stimulating effect on the Exo-PG biosynthesis. Catabolic repression could be one of the reasons for this reduction in Exo-PG fermentation which further suggests and concludes that wheat bran is a naturally carbon-enriched agricultural substrate. Balachandran et al. [37] investigated the effect of carbon sources on protease yield by incubating the SSF cultural bed after supplementation of various carbon sources. In their study, the maximum protease yield (387.64 U/mL) was observed to be in the presence of sucrose supplemented to SSF medium after 2 days of fermentation. Significant effect of various carbon sources has also been observed by [38], leading towards the increased yield of alkaline protease production.
3.1.2 Effect of salt sources on exo-polygalacturonase biosynthesis
The addition of salts had a favorable effect on enzyme activity, and enzyme production was meaningfully improved by the supplementation of different metal salts. Salt in micro-amounts provides many functions in the fermentation process: It helps in the better supply, extraction and solubilization of nutrients from biomass/agricultural waste material to be used by fermenting organisms which in turn further enhances the yield of enzyme. Results revealed a significant increase in enzyme titer by the addition of manganese sulfate (Fig. 3). Other salts positively affected enzyme productivity because of the accessibility of vital nutrients necessary for appropriate fungal growth, resulting in enhanced enzyme production. Improved activity profile following salt inclusion was attributed to the enhanced regulation of relevant genes during transcription [5]. MnSO4 was also an active enzyme stimulator [39].
3.2 Immobilization of exo-polygalacturonase
Exo-polygalacturonase was immobilized on magnetic nanoparticles via covalent bonding by using a macromolecular crosslinker, polyaldehyde dextran. Oxidized dextran having reactive aldehyde groups could carry out the cross-linking reaction of amino groups present in amino acid groups of enzyme molecule and chitosan, preventing the leaking/leaching of enzyme molecule during reaction [29]. Optimized values for the immobilization, i.e., various crosslinking parameters and amount of non-catalytic support presented by Sojitra et al. [29], were utilized in this immobilization of exo-polygalacturonase on chitosan magnetic nanoparticles. The resulting performance efficacy of the immobilized biocatalyst was presented in terms of immobilization efficiency (IE), apparent activity, and relative activity. Immobilization of enzyme is usually accompanied by problems like enzyme leaking, resistance in protein transfer to support material and enzyme deactivation. However, our study obtained promising results, indicating a good IE of 77% and 3.1 mg protein loading per gram of nanoparticles. The apparent activity of immobilized exo-polygalacturonase was noted to be 25.7 U/g, with a relative activity of 45% (Table 1).
3.3 Characterization of free and immobilized Exo-PG
3.3.1 Effect of metal/non-metal ions on the soluble form of Exo-PG activity
The impact of diverse metal ions on the biocatalytic activity of exo-polygalacturonase was assessed just to see the involvement of any cofactors in the active site of the enzyme (Fig. 4). From the results, it can be seen that NH4+ and Mg+2 ions significantly enhanced the enzyme activity greatly; this result was found to be consistent with previous studies [7, 40]. K+ and Na+ also stimulated the enzyme activity, and these results were in accordance with [41] and [7], which indicated the possibility of their action as salt or ion bridges that stabilize the biocatalyst in its active site conformation to approach and hold the substrate better and further hydrolysis and might also protect the enzyme against it thermal inactivation. This result suggests that the exo-polygalacturonase produced in our study can be a possible complex protein, which requires a cofactor to perform better as a biocatalyst to show higher activities or this enhanced enzyme bioactivity under the presence of these ions may be due to charge neutralization by Na+ and K+ on the polymeric pectin to minimize the repulsive forces between the pectin polymer and overall negative charge of the enzymatic protein. Other ions like Fe+2 and Mn+2 also moderately stimulated the exo-polygalacturonase activity, which was consistent with [42] and [11], while Zn+ and Mn+2 slightly increased the enzyme activity.
3.3.2 Optimum pH and stability of free and immobilized Exo-PG
In the enzyme activity profile for pH, it was observed that there were variations in the values. A pH of 3.5 was found to be optimum for this particular exo-polygalacturonase which was in consistent with [43]. Whereas from the pH stability graph trend, it can be seen and clearly concluded that this enzyme showed stability at a wider range of pH 3.0–7.0 (Fig. S1). Previous reports have revealed the pH stability for the enzyme between pH 2.5–12. Exo-polygalacturonase after immobilization showed a shift in pH optima, and it was found to be 6.5. This change in pH optima of immobilized enzyme could result from conformational changes and microenvironment change in enzyme after immobilization [20, 44]. The change in pH after immobilization could be the result of the nature of immobilization support. Similarly, immobilized exo-polygalacturonase showed pH stability over a very broad range of pH, especially in acidic regions, making it an excellent candidate for food industry applications. This may be due to a reason, in the mildly acidic region, nanocatalysts provide the favorable environment for the pectinase to act against pectin leading to increased affinity of enzyme towards its substrate. Therefore, the immobilized enzyme exhibits good adaptability to environmental acidity and reveals acceptable pH stabilities over a broad experimental range. Our results are consistent with [6, 7, 44,45,46], where higher PG activity was obtained at an acidic pH range.
3.3.3 Temperature optima and Ea profiles of exo-polygalacturonase for substrate hydrolysis
The effect of elevated temperatures (35–80 °C) on the bioactivity of the free and immobilized form of exo-polygalacturonase was studied in detail to assess its potential for drastic industrial environments. The free and immobilized enzyme temperature optima were found at 35 °C and 40 °C, respectively (Figs. 5 and S2). The free enzyme’s maximum activity was found to be up to 35 °C, after which the enzyme activity decreased, showing that enzymes started denaturing at elevated temperatures. The immobilized enzyme showed maximum activity up to 40 °C. After that, the immobilized enzyme activity started decreasing, but the decline in activity after immobilization was slower as compared to the soluble form of enzyme, indicating the stability of immobilized enzyme at higher temperature with 2.76% and 7.95% enhanced stability at 55 °C and 80 °C, respectively, as compared to soluble counterpart.
The activity and stability at high temperatures could be due to the conformational structure change, which imparted rigidity at elevated temperatures which might be due the creation of the covalent bond between pectinase and nanoparticle surface also leading towards the increased Ea of thermal denaturation reaction. The energy of activation (Ea) for the maximum hydrolysis of substrate in the case of free and immobilized enzyme was found to be 29.57 J/mole and 33.23 J/mole, respectively (Fig. 6). This increase in energy of activation observed in the case of immobilized enzyme showed that the enzyme must have to cross a higher energy barrier to form a transition state complex with its substrate for subsequent hydrolysis into products compared to soluble counterpart. Hence, it requires much more energy to break down their active conformation over the free form. The higher deactivation energy is a well-known parameter of indexing high thermal stability of protein indicating more thermal rigidity during denaturation experiments.
3.3.4 Kinetic parameters
The velocity constant, Vmax, value indicates the maximum biocatalytic rate of degradation of substrate molecule into the final reaction product when all active sites of the enzyme are saturated with substrate molecules. The substrate concentration at half of the velocity constant value is considered the affinity constant (Km) value as per the straight-line form of Michealis-Menten equation.
A high value of Km indicates the less affinity of the enzyme towards its substrate, which in turn rely on the diffusion frequency of substrate molecules with enzyme, steric effect due to complex structure of substrate and enzyme and as well as the external factors, i.e., pH, temperature, and ionic strength [47].
Kinetic parameters of free and immobilized enzymes were calculated via the Lineweaver–Burk plot. The km value for the free enzyme at different concentrations of pectin (0.1–2.5%) was 0.211 µmole/mL/min, whereas in the case of immobilized counterpart, a lower value was observed, 0.084 µmole/mL/min (Fig. 7). The less km value for immobilized enzyme indicates that immobilized enzyme needs a lower substrate concentration, which might be possible due to greater enhanced accessibility of active sites of enzyme towards its substrate after immobilization, showing increased affinity towards pectin. This low value of Km observed after immobilization could also be attributed to the stabilization of the enzyme active site, leading to more availability of the active sites to substrate molecule [11, 12]. A less value of Km after immobilization is also an indication that this biocatalyst requires less concentration/amount of substrate molecules to gain maximum rate compared to soluble counterpart, which shows the greater affinity of the enzyme towards its substrate. Our results agree with Alagoz et al. [48] who reported the same trend in Km value for immobilized pectinase on modified Florisil and nanosilica supports. Similarly, a lower value of Km after immobilization of pectinase on activated montmorillonite support is also reported by Mohammadi et al. (2020). A total of 24% decline in value of Km was also reported [49] after pectinase immobilization on PEI-PE10% surface.
Vmax values of immobilized exo-polygalacturonase (14.20 µmole/mL/min) was found to be less than that of the soluble form (42.37 µmole/mL/min), which clearly suggests that the rate of substrate hydrolysis was decreased after immobilization. Due to either the constraints faced by substrate molecule in proper diffusion with active site of enzyme or the interaction of substrate with the active functional groups on support material [47]. Our result shows agreement with Oktay et al. [49], who reported a pectinase immobilized on cryogels with a Vmax value lower than the soluble counterpart, which can be attributed to the conformational changes in enzyme structure after immobilization process.
3.3.5 Thermal stability parameters
An enzyme’s thermal firmness/stability is considered one of the most crucial factors because of its use on an industrial scale at which high temperatures are preferred to speed up the reaction to fulfill the daily commercial market demand. So thermal stability of enzymes is of utmost importance with respect to its implementation at a commercial industrial scale. Thermal stability represents the capacity of an enzyme molecule to resist its unfolding in the absence of substrate at a higher temperature, while thermophilicity is the ability of an enzyme to work at higher temperatures in the presence of substrate molecules. In case of thermal stability, the stability of enzymes is always calculated in terms of residual activity.
Thermodynamic parameters, such as half-life, ΔH*, ΔG*, and ΔS* were calculated to study the thermal stability of free and immobilized exo-polygalacturonase (Tables 2 and 3). The thermal stability profile of enzyme is the most important parameter owing to its use on an industrial scale. The increase in enthalpy, half-life, and activation energy and decrease in entropy could be due to the conformational changes after immobilization of exo-polygalacturonase. Immobilized enzyme showed more stability as compared to the free enzyme, as indicated by the data of high enzyme functional activity compared to free exo-polygalacturonase. At 50 °C both free and immobilized exo-polygalacturonase retained more than 97% of activities after 60 min of incubation, while at 80 °C soluble and immobilized form retained 93% of activities after 60 min of incubation which shows a very good stability profile of this enzyme at higher temperatures.
Ea for denaturation was found to be 29.66 J/K/mole and 33.17 J/K/mole in the case of free and immobilized counterparts. These low values of Ea calculated from Arrhenious plot (from the slopes of the straight lines obtained plotting lnkd vs. (1/T)1000) for both exo-polygalacturonase (free and immobilized) are an indication of the fact that it showed more stability, compactness, showing resistance to confirmational unfolding during heat denaturation experiments in comparison with the free counterparts [11, 12, 14, 50]. A similar trend of increase in Ea was reported by Oliveira et al. [50] for immobilization of pectinase in alginate beads compared to free enzyme. A higher value of half-life in the case of immobilized exo-polygalacturonase was observed for all values of temperatures except for 40 °C and 80 °C as compared to free counterparts, which showed its higher stability at elevated temperatures. The increase of t1/2 values after immobilization might be due to the protection of the enzyme molecules by the support matrix so that enzyme was not more flexible enough in aqueous media leading towards decreased protein unfolding; as a result, the stability of the immobilized enzyme was increased. A total of 27% boost in value of half-life was observed at 50 °C, while 16% increase was observed at 70 °C after immobilization. The same increase in half-life values after enzyme immobilization had been observed in our previous findings reported in 2017 [20]. However, our results are in contradiction with Oliveira et al. [43], which showed a decline in half-life after immobilization of pectinase on alginate beads.
Ea for thermal denaturation is linked directly with enthalpy of deactivation (ΔH*), another important thermodynamic parameter expressing the total energy required to denature the enzyme. ΔH* and ΔS* provide information about the number of hydrogen bonds broken and the net solvent-enzyme disorder change associated with thermal inactivation, respectively. The large values of deactivation enthalpy (ΔH*) are characteristic of resistance of protein unfolding during denaturation reaction [20, 45, 50]. The higher values of ΔH* was observed in this case for immobilized exo-polygalacturonase due to the conformational changes after immobilization, indicating the resistance of enzyme against thermal unfolding. A similar increase in ΔH* values was observed in the case of lipase immobilized on MANAE-agaros compared to the free counterpart [51].
The other most important thermodynamic parameters, ΔG* and ΔS* (Gibbs free energy of activation and entropy of activation of denaturation reaction), are also excellent factors for the explanation of the enzyme thermal stability profile [20, 50, 51]. The Gibbs free energy of enzyme molecule results from the weaker intermolecular forces present in protein’s tertiary structure, which participates in overall protein stability; these forces include hydrogen bonding and Van der Waals forces. Smaller or negative values of Gibbs free energy are associated with the spontaneity of the denaturation process of enzyme molecules at elevated temperatures and an indication of less stability, whereas higher value of ΔG* reveals better resistance and non-spontaneity of the protein denaturation during thermal unfolding [20, 50, 51]. The ΔG* values obtained for the immobilized biocatalyst were higher than those obtained for the soluble enzyme, but the values decreased with the increase in temperature, indicating that weaker intermolecular forces participating in the quaternary level of organization of protein are disturbed leading towards an increase in the thermal unfolding of the protein at higher temperatures. Our results agree with [50]. Entropy values were found to be negative and much lower than free enzyme, signifying that immobilization imparted orderness and hence thermal stability in the system. With the rise of temperature, entropy showed a decreasing trend due to compaction/aggregation of the enzyme molecules at higher temperatures.
3.4 Reusability of immobilized enzyme
The reusability of immobilized pectinase is one of the most essential features for industrial-scale exploitations. The reusability of immobilized pectinase in 1st batch of the cycle was declared 100% by comparing with other batch reactions. In the 2nd and 3rd reuse cycles, enzyme lost 2% and 11% of its initial activities. In the 4th cycle of reuse, it showed maximum retention of activity up to a value of 63%. However, it started decreasing afterwards and showed a low relative activity of 22% in the 7th cycle of reuse (Fig. 8). The decline in activity of immobilized enzymes might probably be attributed to conformational alteration in the enzymatic protein, or the leaching of the enzyme from the carrier surface, or the loss of the immobilized enzyme particles during the magnetic recovery process.
3.5 Application of Exo-PG on fruit juice clarification
Crude fruit juices samples were incubated with the free enzyme for 1 h, and the competencies were investigated in terms of clarification and viscosity as compared to untreated control juice samples (Figs. 9 and S3). Untreated juice samples possess greater values for viscosities due to the presence of pectinaceous materials, and its Exo-PG treatments resulted in up to 37.6%, 18.2%, and 51.6% 44.2% decrease in viscosity of apple, pineapple, grapes, and pomegranate juices, respectively. Polymeric pectin always has a very high capacity for water-holding and growing in a structure having cohesive networking. These pectinaceous substances are focused on degradation by the pectic enzymes leading to decreased water holding capacity and subsequent release of free water to the system, increasing volume, and decreasing the level of viscosity [52]. These results were similar to [20] and [7]. The volume of all the fruit juices changed after free Exo-PG treatment. The release of water molecules can explain volume change retained within pectin molecules. The volume increased by 7.7%, 5.8%, 9.5%, and 1.9% in pomegranate, apple, grapes, and pineapple, respectively. Clarity measurement of four juices was determined before and after Exo-PG. There was 93.6% transmittance in grape juice, 92.9% in apple, 59.4% in pineapple, and 83.8% more transmittance in pomegranate as compared to fresh juice. These results were consistent with earlier reports [46, 53].
3.6 Antioxidant profile and total phenolic contents of juices before and after enzyme treatment
Antioxidant capacity of apple, grapes, pineapple, and pomegranate was checked before and after enzyme treatment (Fig. 10). Results show that pomegranate has the highest antioxidant activity with a 255% increase followed by pineapple, apple, and grapes with 242%, 172%, and 76% increase respectively in antioxidant profile after exo-polygalacturonase treatment. This increase in antioxidant activity is mainly due to their release in the juice, which is trapped in pectin molecules upon degradation after enzyme treatment. Total phenolic contents of apple, grapes, pineapple, and pomegranate were also observed before and after exo-polygalacturonase treatment, which showed an increase in phenolic contents maximum up to 18% after enzyme treatment in the case of grapes juice, while 14% enhancement was observed in case of apple and pomegranate. This increase in TPC content can be explained by the release of some phenolic compound entrapped between pectin molecules readily available for consumption after Exo-PG treatment.
4 Conclusion
Exo-PG was produced through solid-state fermentation technology by Penicillium paxilli. Yeast extract, pectin, and manganese sulfate were found to be significant factors affecting exo-polygalacturonase production. Biochemical characterization of both free and immobilized exo-polygalacturonase showed temperature optima of 35 °C and 40 °C, while pH optima that was observed for both free and immobilized exo-polygalacturonase was 3.5 and 6.5, respectively. The overall study of thermodynamic and kinetic parameters presented a very good profile of this enzyme before and after immobilization, which renders it an excellent candidate for hard industrial environments. Fruit juice industry potential assessment was made via studying the effect of exo-polygalacturonase on different fruit juices via physical and nutritional parameters. In conclusion, the result suggests that Penicillium paxilli pectinase is an excellent candidate that can be successfully used in the fruit juice clarification industry to enhance physical and nutritional characteristics in final juice product of final juice product industry.
Data availability
Not applicable.
References
Sandri IG, Fontana RC, Barfknecht DM, Silveira MM (2011) Clarification of fruit juices by fungal pectinases. LWT Food Sci Technol 44(10):2217–2222
Ahmed I, Zia MA, Hussain MA, Akram Z, Naveed MT, Nowrouzi A (2016) Bioprocessing of citrus waste peel for induced pectinase production by Aspergillus niger; its purification and characterization. J Radiat Res Appl Sci 9(2):148–154
Teixeira MF, Lima FJL, Duran N (2000) Carbon sources effect on pectinase production from Aspergillus japonicus 586. Braz J Microbiol 31(4):286–290
Jayani RS, Saxena S, Gupta R (2005) Microbial pectinolytic enzymes: a review. Process Biochem 40(9):2931–2944
Amin F, Bhatti HN, Bilal M, Asgher M (2017) Multiple parameter optimizations for enhanced biosynthesis of exo-polygalacturonase enzyme and its application in fruit juice clarification. Inte J Food Eng 13(2)
Ma YP, Hao H, Chen Z, Zhao Z, Chen S, Sunc S, Xu C (2017) Production, purification and physicochemical properties of an exo-polygalacturonase from Aspergillus niger SW06. J Braz Chem Soc 28(4):622–628
Lu X, Lin J, Wang C, Du X, Cai J (2016) Purification and characterization of exo-polygalacturonase from Zygoascus hellenicus V25 and its potential application in fruit juice clarification. Food Sci Biotechnol 25(5):1379–1385
Ma Y, Sun S, Hui H, Xu H (2016) Production, purification and characterization of an exo-polygalacturonase from Penicillium janthinellum SW09. An Acad Bras Ciênc 88:479–487
Ridley BL, O’Neill MA, Mohnen D (2001) Pectins: structure, biosynthesis, and oligogalacturonide-related signaling. Phytochemistry 57(6):929–967
Shet AR, Desai SV, Achappa S (2018) Pectinolytic enzymes: classification, production, purification and applications. Res J Life Sci Bioinform Pharm Chem Sci 4:337–348
Amin F, Mohsin A, Bhatti HN (1868) Bilal M (2020) Production, thermodynamic characterization, and fruit juice quality improvement characteristics of an Exo-polygalacturonase from Penicillium janczewskii. Biochim Biophys Acta (BBA) Proteins and Proteomics 5:140379
Amin F, Arooj T, Nazli ZH, Bhatti HN, Bilal M (2021) Exo-polygalacturonase production from agro-waste by Penicillium fellutanum and insight into thermodynamic, kinetic, and fruit juice clarification. Biomass Conversion Biorefinery. https://doi.org/10.1007/s13399-021-01902-2
Contesini FJ, Figueira JA, Kawaguti HY, Fernandes PCB, Carvalho PO, Nascimento MG, Sato HH (2013) Potential applications of carbohydrases immobilization in the food industry. Int J Mol Sci 14:1335–1369
Yang J, Luo H, Li J, Wang K, Cheng H, Bai Y, Yuan T, Fan Y, Yao B (2011) Cloning, expression and characterization of an acidic endo-polygalacturonase from Bispora sp. MEY-1 and its potential application in juice clarification. Process Biochem 46:272–277
Gummadi SN, Panda T (2003) Purification and biochemical properties of microbial pectinases: a review. Process Biochem 38:987–996
Rodrigues RC, Berenguer-Murcia A, Carballares D, Morellon-Sterling R, Fernandez-Lafuente R (2021) Stabilization of enzymes via immobilization: multipoint covalent attachment and other stabilization strategies. Biotechnol Adv 52:107821
Monteiro RRC, Arana-Pena S, da Rocha TN, Miranda LP, Berenguer-Murcia A, Tardioli PW, dos Santos JCS, Fernandez-Lafuente R (2021) Liquid lipase preparations designed for industrial production of biodiesel. Is it really an optimal solution? Renew Energy 164:1566–1587. https://doi.org/10.1016/j.renene.2020.10.071
Sheldon RA (2007) Enzyme immobilization: the quest for optimum performance. Adv Synth Catal 349:1289–1307
Sheldon RA, Pelt SV (2013) Enzyme immobilization in biocatalysis: why, what and how. Chem Soc Rev 42:6223
Amin F, Bhatti HN, Bilal M, Asgher M (2017) Improvement of activity, thermo-stability and fruit juice clarification characteristics of fungal exo-polygalacturonase. Int J Biol Macromol 95:974–984
Tan Z, Zhou J, Li X, Ren S, You Q, Bilal M (2021) Immobilization of a cold-adaptive recombinant Penicillium cyclopium lipase on modifed palygorskite for biodiesel preparation. Biomass Conversion Biorefnery. https://doi.org/10.1007/s13399-021-02006-7
Bayramoglu G, Celikbicak O, Kilic M, Arica MY (2022) Immobilization of Candida rugosa lipase on magnetic chitosan beads and application in flavor esters synthesis. Food Chem 366:130699
Boudrant J, Woodley JM, Roberto FL (2020) Parameters necessary to define an immobilized enzyme preparation. Process Biochem. https://doi.org/10.1016/j.procbio.2019.11.026
Virgen-Ortíz JJ, dos Santos JCS, Berenguer-Murcia A, Barbosa O, Rodrigues RC, Fernandez-Lafuente R (2017) Polyethylenimine: a very useful ionic polymer in the design of immobilized enzyme biocatalysts. J Mater Chem B 5:7461–7490. https://doi.org/10.1039/C7TB01639E
Badoei-dalfard A, Tahami A, Karami Z (2021) Lipase immobilization on glutaraldehyde activated graphene oxide/chitosan/cellulose acetate electrospun nanofibrous membranes and its application on the synthesis of benzyl acetate. Colloids Surf B. https://doi.org/10.1016/j.colsurfb.2021.112151
Liu DM, Chen J, Shi YP (2018) Advances on methods and easy separated support materials for enzymes immobilization. TrAC Trends Anal Chem 102:332–342
Husain Q (2017) Nanomaterials as novel supports for the immobilization of amylolytic enzymes and their applications: a review. Biocatalysis 3(1):37–53
Zhao J, Ma M, Yan X, Wan D, Zeng Z, Yu P, Gong D (2022) Immobilization of lipase on β-cyclodextrin grafted and aminopropyl-functionalized chitosan/Fe3O4 magnetic nanocomposites: an innovative approach to fruity flavor esters esterification. Food Chem 366:130616
Sojitra UV, Nadar SS, Rathod VK (2017) Immobilization of pectinase onto chitosan magnetic nanoparticles by macromolecular cross-linker. Carbohyd Polym 157:677–685
Bhatti HN, Rashid MH, Nawaz R, Perveen R, Jabbar A, Asgher M (2007) Purification and characterization of a novel glucoamylase from Fusarium solani. Food Chem 103:338–343
Miller GL (1959) Use of dinitrosalicylic acid reagent for determination of reducing sugar. Anal Chem 31(3):426–428
Bradford M (1976) A rapid and sensitive method for the quantitation of microgram quantities of protein utilizing the principle of protein-dye binding. Anal Biochem 72:248–254
Saxena S, Gautam S, Sharma A (2010) Physical, biochemical and antioxidant properties of some Indian honeys. Food Chem 118(2):391–397
Noor N, Sarfraz RA, Ali S, Shahid M (2014) Antitumour and antioxidant potential of some selected Pakistani honeys. Food Chem 143:362–366
Kar S, Ray RC (2011) Purification, characterization and application of thermostable exo-polygalacturonase from Streptomyces erumpens MTCC 7317. J Food Biochem 35(1):133–147
Darah I, Taufiq M, Lim S (2013) Pomelo Citrus grandis (L.) osbeck peel as an economical alternative substrate for fungal pectinase production. Food Sci Biotechnol 22(6):1683–1690
Balachandran C, Vishali A, Nagendran NA, Baskar K, Hashem A, Abd Allah HA (2021) Optimization of protease production from Bacillus halodurans under solid state fermentation using agrowastes. Saudi J Biol Sci 28:4263–4269
Malathi S, Chakraborty R (1991) Production of alkaline orotease by a new Aspergillus flavus isolate under solid-substrate fermentation conditions for use as a depilation agent. Appl Environ Microbiol 57(3):712–716
Kashyap D, Vohra PK, Chopra S, Tewari R (2001) Applications of pectinases in the commercial sector: a review. Biores Technol 77(3):215–227
Pedrolli DB, Carmona EC (2010) Purification and characterization of the exopolygalacturonase produced by Aspergillus giganteus in submerged cultures. J Ind Microbiol Biotechnol 37(6):567–573
Anand G, Yadav S, Yadav D (2017) Purification and biochemical characterization of an exo-polygalacturonase from Aspergillus flavus MTCC 7589. Biocatal Agric Biotechnol 10:264–269
Gomes E, Leite RSR, Silva RS, Silva D (2009) Purification of an exopolygalacturonase from Penicillium viridicatum RFC3 produced in submerged fermentation. Int J Microbiol 2009:631942
Pan X, Li K, Ma R, Shi P, Huang H, Yang P, Meng K, Yao B (2015) Biochemical characterization of three distinct polygalacturonases from Neosartorya fischeri P1. Food Chem 100(188):569–575
Esawy MA, Gamal AA, Kamel Z, Ismail AM, Abdel-Fattah A (2013) Evaluation of free and immobilized Aspergillus niger NRC1ami pectinase applicable in industrial processes. Carbohyd Polym 92(2):1463–1469
Amin F, Bhatti HN, Bilal M, Asgher M (2017) Purification, kinetic, and thermodynamic characteristics of an exo-polygalacturonase from Penicillium notatum with industrial perspective. Appl Biochem Biotechnol 183(1):426–443
Patidar MK, Nighojkar S, Kumar A, Nighojkar A (2016) Papaya peel valorization for production of acidic pectin methylesterase by Aspergillus tubingensis and its application for fruit juice clarification. Biocatal Agric Biotechnol 6:58–67
Mohammadi M, Mokarram RR, Shahvalizadeh R, Sarabandi K, Lim LT, Hamishehkar H (2020) Immobilization and stabilization of pectinase on an activated montmorillonite support and its application in pineapple juice clarification. Food Sci 36:100625.41
Alagöz D, Tükel SS, Yildirim D (2016) Immobilization of pectinase on silica based supports: Impacts of particle size and spacer arm on the activity. Int J Biol Macromol 87:426–432
Oktay B, Demir S, Kayaman-Apohan N (2020) Immobilization of pectinase on polyethyleneimine based support via spontaneous amino-yne clickreaction. Food Bioprod Process 122:159–168
Oliveira RL, Silva OS, Converti A, Porto TS (2020) Thermodynamic and kinetic studies on pectinase extracted from Aspergillus aculeatus: Free and immobilized enzyme entrapped in alginate beads. Int J Biol Macromol 115:1088–1093
Ferreira MM, Santiago FLB, Silva NA, Luiz JHH, Fernandéz-Lafuente R, Mendes AA, Hirata DB (2018) Different strategies to immobilize lipase from Geotrichum candidum: Kinetic and thermodynamic studies. Process Biochem 67:55–63
Garzon CD, Habrylo O, Lemaire A, Guillaume A, Carré Y, Millet C, Pelloux J (2021) Characterization of a novel strain of Aspergillus aculeatinus: From rhamnogalacturonan type I pectin degradation to improvement of fruit juice filtration. Carbohydr Polym 262:117943
Sandri GI, Fontana RC, Barfknecht DM, Silveira MM (2011) Clarification of fruit juices by fungal pectinases. LWT Food Sci Technol 44(10):2217–2222
Funding
The authors received financial support from the Government College Women University, Faisalabad, Pakistan, under in-house research grant program.
Author information
Authors and Affiliations
Contributions
Conception and design of study, Faiza Amin, Haq Nawaz Bhatti; Investigation, Syeda Anam Asad; Formal analysis and data curation, Umme Kalsoom, Zill-i-Huma Nazli; Software and validation, Faiza Amin, Muhammad Bilal; Writing—review and editing, Faiza Amin, Muhammad Bilal; Supervision, Faiza Amin. All authors have read and approved the final manuscript.
Corresponding authors
Ethics declarations
Conflict of interest
Not applicable.
Additional information
Publisher’s note
Springer Nature remains neutral with regard to jurisdictional claims in published maps and institutional affiliations.
Supplementary Information
Below is the link to the electronic supplementary material.
Rights and permissions
About this article
Cite this article
Amin, F., Asad, S.A., Nazli, ZiH. et al. Immobilization, biochemical, thermodynamic, and fruit juice clarification properties of lignocellulosic biomass–derived exo-polygalacturonase from Penicillium paxilli. Biomass Conv. Bioref. 13, 13181–13196 (2023). https://doi.org/10.1007/s13399-022-02559-1
Received:
Revised:
Accepted:
Published:
Issue Date:
DOI: https://doi.org/10.1007/s13399-022-02559-1